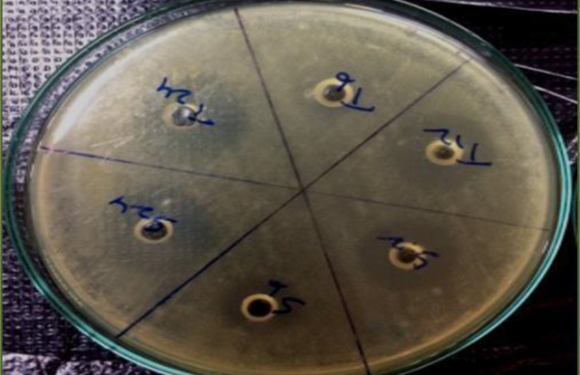
Development and Validation of Microbiological Analytical  Method for Determination of Potency of Voriconazole Tablets

Published on:July 2020 Journal of Young Pharmacists, 2020; 12(2s):s102-s107 Original Article | doi:10.5530/jyp.2020.12s.56 Authors: T. Veena Priyanka Anand*, S. Kavya Sree, S. Pavani, G. Manju Bhargavi, Shubham Babu Gupta Pharm D, Malla Reddy Institute of Pharmaceutical Sciences, Dhulapally, Hyderabad, Telangana, INDIA. Abstract:…